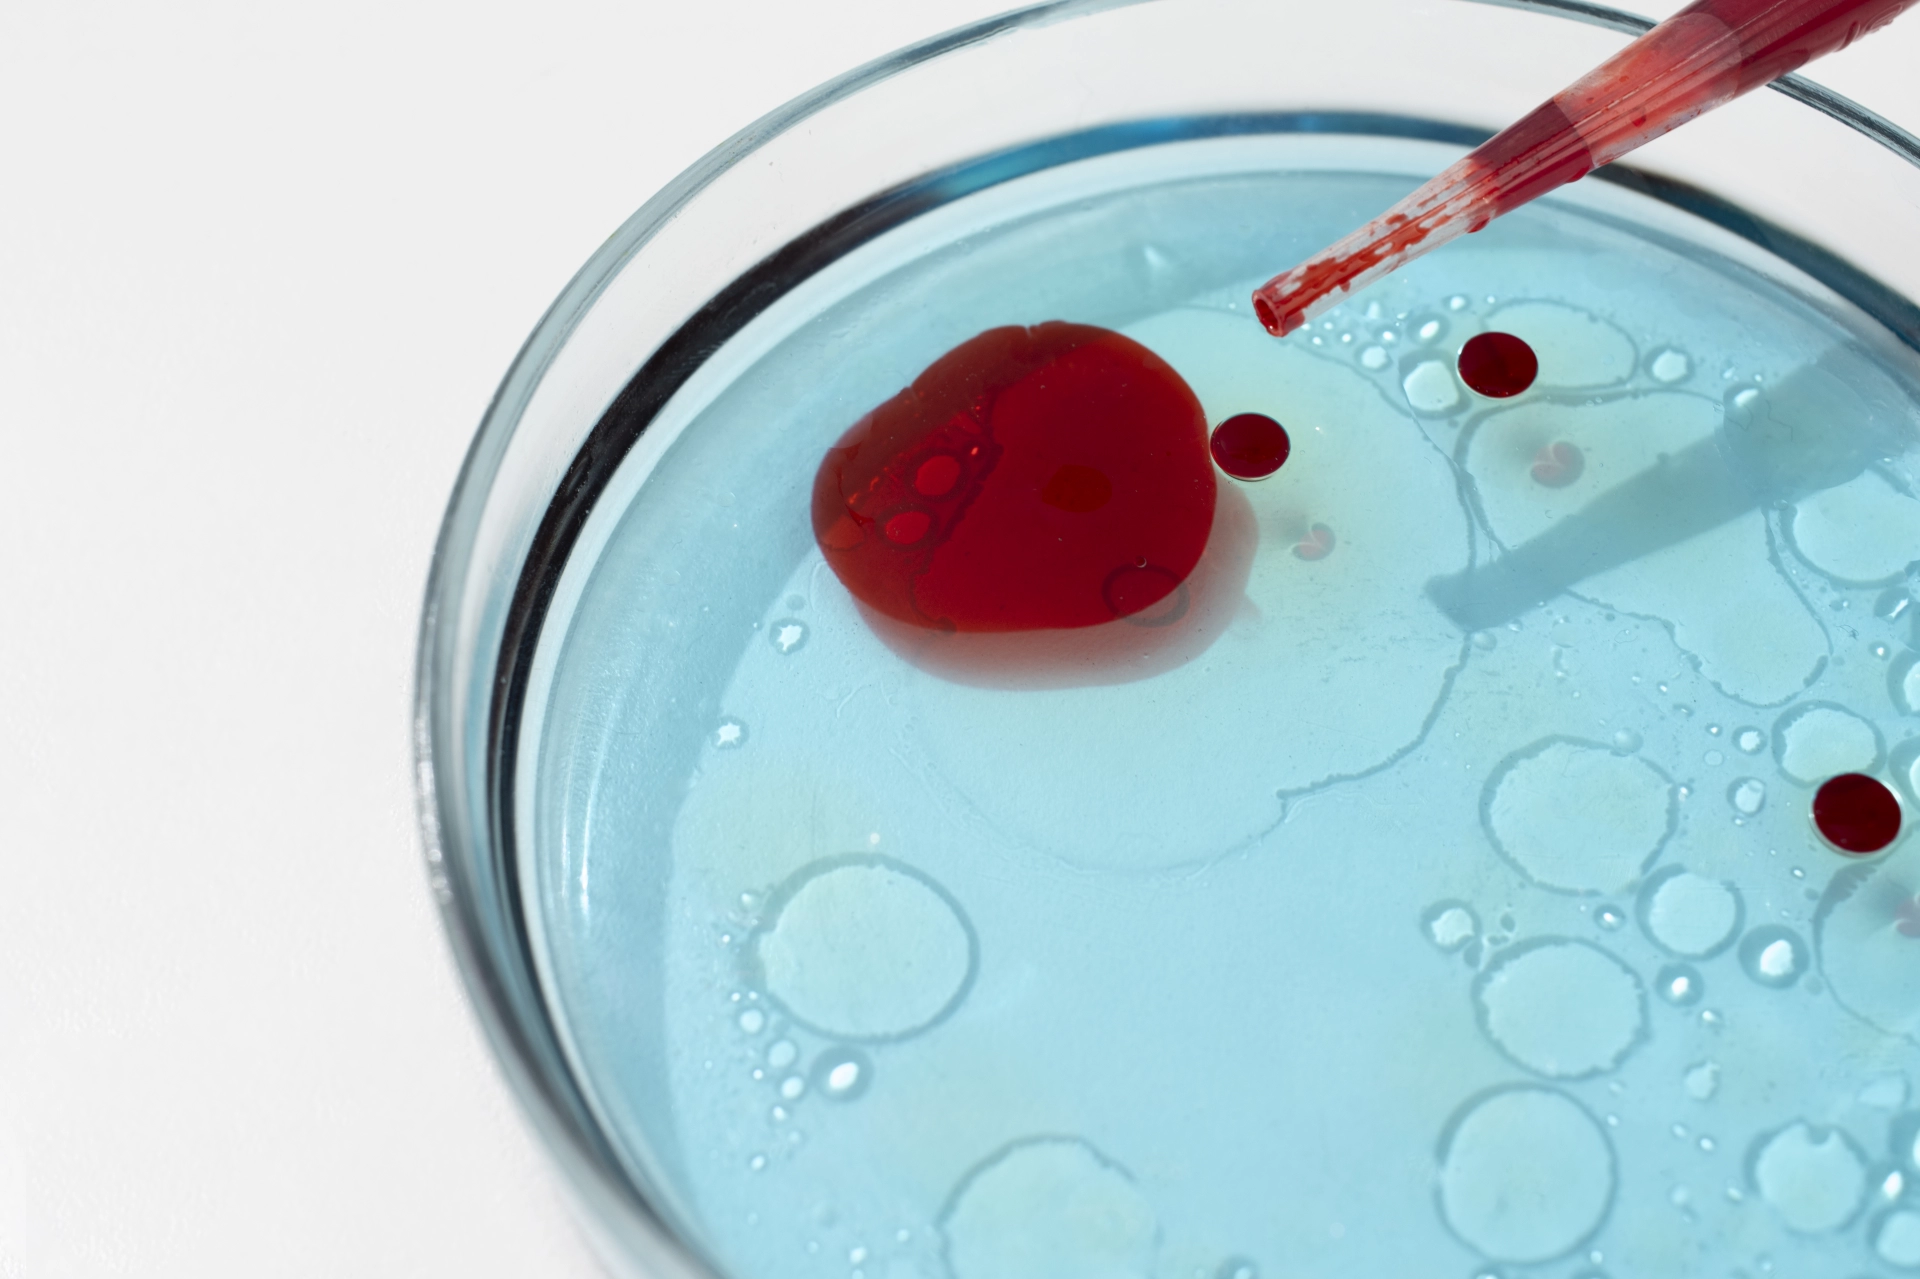
Що таке коагулограма

- >
- >
- >
Коагулограма (аналіз на згортання крові)
Система згортання крові – захисна реакція організму, що запобігає значній крововтраті й виникненню тромбозів. Гемостазіологічні дослідження спрямовані на визначення високої чи низької здатності крові до коагуляції (згортання). Здати коагулограму в Харкові можна в «Європейському Радіологічному Центрі».
Що таке коагулограма
Коагулограма (оцінка гемостазу) – це дослідження системи зсідання крові (коагуляції). Включає в себе характеристики оцінки рівноваги антикоагулянтної системи крові. Згортання крові впливає на гемостаз і фібриноліз.
Гемостаз крові – біологічна система, що забезпечує збереження крові в рідкому стані, а також попереджає та зупиняє кровотечі, підтримуючи цілісну структуру кровоносних судин. Підтипи гемостазу:
- первинний (початковий, судинно-тромбоцитарний) гемостаз. Виникає через звуження просвіту між стінками судин і призводить до їх непрохідності через тромбоцити протягом однієї-трьох хвилин;
- вторинний (плазмовий, коагуляційний) гемостаз. Під час плазмового гемостазу процеси згортання фібрину утворюють закупорку пошкоджених судин тромбом – згустком крові, до складу якого входять тромбоцити, білки плазми крові. Вторинний гемостаз зупиняє кровотечу шляхом виникнення фібринових тромбів.
Фібриноліз (розчинення згустку крові) – перетворення невеликої кількості фібриногену на розчинний фібрин, головною функцією якого є компенсація просвіту закупореної кровоносної судини. При зсіданні фібриноліз не дозволяє порушити мікроциркуляцію, створює реканалізацію (розсмоктування) тромбу та відновлює кровоток у віддалених тканинах.
Показання до коагулограми (аналізу на густину крові)
Коагулограма показує особливості функціонування системи гемостазу. У коагулограму входять:
- протромбін (за Квіком, протромбіновий час);
- активований частковий тромбопластиновий час (АЧТЧ);
- фібриноген;
- тромбіновий час;
- МНВ – міжнародне нормалізоване відношення.
МНВ – показник, що використовується в коагулограмі для оцінювання часу зсідання крові в пацієнта, який приймає пероральні антикоагулянти. У нормі МНВ знаходиться в межах 0,8-1,2.
| Таблиця норми коагулограми | ||
| Показник коагулограми | Опис | Норма |
| Фібриноген | Фібриноген синтезується в печінці, є фактором згортання плазми крові. Також фібриноген бере участь у приєднанні тромбоцитів, визначає в'язкість крові та впливає на взаємодію формених елементів крові з судинною стінкою. Фібриноген належить до білків запалення, його підвищені значення в коагулограмі призводять до зниження електричного заряду еритроцитів та збільшення швидкості осідання еритроцитів (ШОЕ). | 2-4 г/л (до 6 г/л під час вагітності) |
| Активований частковий тромбопластиновий час | Використовується для скринінгу оцінки зсідання крові, для контролю пацієнтів, які приймають препарати з діючою речовиною гепарином. Тест визначає час утворення згустку крові після додавання спеціальних реагентів. Відхилення від норми (зменшення) АЧТЧ свідчить про підвищене згортання крові та схильність до тромбоутворення, збільшення – про знижене згортання та схильність до кровотеч. | 30-40 сек. |
| Тромбіновий час | Час, необхідний для формування фібринового згустку при додаванні до плазми тромбіну – ферменту, що виникає при взаємодії факторів зсідання крові при пошкодженні судини. | 11-18 сек. |
| Протромбіновий індекс | Протромбіновий індекс (ПТІ) – співвідношення часу згортання плазми здорової людини та часу згортання досліджуваної плазми. Протромбін виробляється за участю вітаміну К у печінці людини. Відхилення ПТІ від норми в коагулограмі у більшу сторону вказує на ризик тромбозу. | 93-100% |
| Вовчаковий антикоагулянт | Вовчакові антикоагулянти – аутоімунні антитіла, що продукуються імунною системою проти власних фосфоліпідів та пов'язаних з ними білків. Фосфоліпіди знаходяться на поверхні тромбоцитів та сприяють активуванню коагуляційних факторів у відповідь на пошкодження кровоносних судин або тканин. Вовчакові антикоагулянти збільшують ризик появи тромбів у венах та артеріях (найчастіше у венах ніг – тромбоз глибоких вен). | 0,8-1,2 ум. од. |
Вовчакові антикоагулянти збільшують ризик появи тромбів у венах та артеріях (найчастіше у венах ніг – тромбоз глибоких вен). Тромби здатні блокувати потік крові в будь-якій частині тіла, що може призводити до серцевих нападів, інфарктів, емболії легень, а також до переривання вагітності, особливо в другому та третьому триместрах вагітності. Однак антикоагулянти також можуть бути присутніми в пацієнтів з аутоімунними та онкологічними захворюваннями, СНІДом, запаленнями.
Д-димер не є спеціальним показником венозної тромбоемболії, його підвищення спостерігається при станах, що супроводжуються активацією зсідання на розчинення тромбів. У нормі не перевищує 500 нг/мл.
Аналіз коагулограма призначається при підозрі на запальний процес в організмі, патології кровоносних судин (звуження, закупорку), захворювання печінки, порушення імунної системи. При ковіді коагулограма здається для оцінювання ризику тромбозу через порушення згортання крові. Коагулограма також проводиться перед хірургічними втручаннями з метою оцінювання ризику кровотечі під час операції.
Коагулограма при вагітності призначається з метою оцінювання ризику тромбоутворення. У вагітних ймовірність утворення тромбів підвищується через зміну рівня гормонів, відповідальних за згортання крові білків, збільшення об’єму крові та тиску на вени.
Підготовка до коагулограми
Спеціальна підготовка до коагулограми не потрібна. Здавати коагулограму натщесерце не обов'язково, пити воду можна в звичайній кількості. Перед здачею аналізу на згортання крові необхідно повідомити лікарю про лікарські препарати, що приймаються, і які можуть вплинути на результати (наприклад, антикоагулянти).
Коагулограма (аналіз на згортання крові) в Харкові
При коагулограмі кров беруть з вени. Результати аналізу на густину крові не є діагнозом, тому при отриманні необхідно проконсультуватися з терапевтом. Лікар проведе розшифровку коагулограми та за необхідності призначить медикаментозну терапію.

Записатися на коагулограму крові в Харкові в «Європейському Радіологічному Центрі» можна за телефоном, вказаним на сайті. Уточнити ціну коагулограми можна також за телефоном.
Вартість послуг

Клініка доказової медицини:
- ✓ Профілактика
- ✓ Комплексна діагностика
- ✓ Лікування
- ✓ Хірургія
- ✓ Реабілітація



























